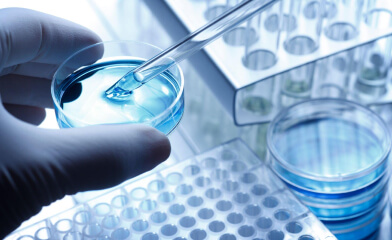
thumbnail

Integrating business using
transport and logistics
We specialize in providing one-stop service for sea and land transportation of dangerous goods and general cargo in domestic and international market.

Logistics Services
Transportation, inventory management, warehousing, order fulfilment, and information flow coordination are all important parts of logistics services. The goal is to optimize these processes in order to reduce costs, improve delivery time, and boost overall customer happiness.
Oleochemical Supply
Oleochemicals are generated from triglycerides present in fats and oils, which are primarily sourced from plant oils (such as palm, coconut, soybean, and sunflower oils) and animal fats (such as tallow and lard). Oleochemicals include a wide range of compounds such as fatty acids, fatty alcohols, fatty acid esters, glycerin, and other derivatives. These substances are used in a variety of industries.
ISOTANK
As one of the leading ISO Tank providers in Indonesia, we are renowned for our expertise in both DG (Dangerous Goods) and non-DG ISO Tank solutions. Our commitment to safety and meticulous separation ensures that we meet the specific requirements of each industry, upholding the highest standards.
ISOTANK Depot
Depot isotanks provide a safe, standardised, and cost-effective method of transporting and storing bulk liquids and gases while complying with safety and environmental regulations.
Flexitank/ Flexibag & CTL Packaging
Our Cakraindo Thermal Liner ensures precise temperature control, safeguarding your cargo from temperature variations during transit. and with our Flexibag/Flexitank your liquid cargo is safely transported in a secure, sealed environment, reducing the risk of contamination and spills.
Trusted Chemical Supply Chain Services for Domestic and International Markets
PT Cakraindo Mitra Internasional is a leading chemical supply chain service provider in Indonesia. Our company provides one-stop service for sea and land transportation of dangerous goods and general cargo in domestic and international market.
Empowering Customers in Multiple Industry Sectors
Chemicals & Petrochemicals
We provide comprehensive solutions for the chemical and petrochemical industry, offering safe and efficient transportation.

Food & Beverage
With a focus on maintaining product integrity, we cater to the food and beverage industry by offering ISO tank services.

Pharmaceuticals and Healthcare
We provide secure transportation of pharmaceuticals, APIs, and healthcare products.

Biotechnology
We take great pride in being the leading logistics company with extensive regional expertise. Cakraindo is dedicated to devising innovative solutions the cater to the diverse needs of our customers across the entire supply chain.
Oil and Gas
At our company, we are proud to offer specialized services for transporting chemicals related to the oil and gas industry. Equipped with cutting-edge technology, our dedicated fleet ensures strict adherence to industry regulations while enabling smooth and efficient logistics operations.

Agriculture and Agrochemicals
We specialize in providing transportation services tailored specifically for the agriculture and agrochemical industries. Our expertise lies in efficiently transporting liquid fertilizer and pesticides such as urea ammonium nitrate (UAN).

National and International Certification
National and International certifications are essential for business continuity because they guarantee
compliance, boost reputation, reduce risks, and increase overall resilience.








